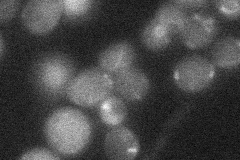

View description
Protein required for normal transcription at several loci including HTA2-HTB2 and HHF2-HHT2, but not required at the other histone loci; functionally related to Spt10p; involved in telomere maintenance
Localization:
Intensity:
Fold change:
Significance:
-
C’ GFP library in SD

nucleus16.22 -
N' NOP1pr-GFP in SD

punctate,nucleus25.1715 -
N' TEF2pr-mCherry in SD

below threshold6.81632 -
N' NATIVEpr-GFP in SD
below threshold18.3375 -
N' TEF2pr-VC and Cyto-VN in SD

#N/A0 -
C’ GFP library in SD+DTT

nucleus17.241.06No -
C’ GFP library in SD+H2O2

nucleus18.461.13No -
C’ GFP library in Starvation Media

nucleus16.281No -
C’ GFP library on the background of Pup2-DaMP

nucleus -
C’ GFP library on the background of CCT mutant

nucleus16.56111.0207No
